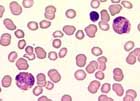

Kurzbeschreibung:
Eine Eosinophilie besteht, wenn die Zahl der eosinophilen Granulozyten >0.4 x109/L beträgt. Die Differentialdiagnose hypereosinophiler Zustände ist sehr gross. Nicht selten persistieren leichtgradige Eosinophilien über lange Zeit, ohne dass eine Ursache gefunden wird und ohne dass es zu Symptomen kommt. Persistiert eine Hypereosinophilie >1.5 x 109/L über mehr als 6 Monate, ohne dass eine Ursache gefunden wird, spricht man von einem Hypereosinophilen Syndrom.
Klinisches Bild:
Die Eosinophilie an sich ist kein Krankheitsbild. Somit ist das klinische Bild abhängig von der jeweiligen Grundkrankheit. Höhergradige Eosinophilien können durch Gewebeinfiltration oder Freisetzung eosinophiler Substanzen wie Zytokinen, Enzymen und anderen Proteinen zu Organschäden führen. Speziell gefürchtet ist dabei die Kardiomyopathie und die Schädigung der Herzklappen, was gelegentlich rasch ein lebensbedrohliches Ausmass annehmen kann. Leider kann nicht vorhergesagt werden, wann dies eintritt und wann Organschäden ausbleiben.
Differentialdiagnose der Eosinophilie:
Hämatologie:
Die Eosinophilie ist in den meisten Fällen mild. Unter Umständen kann sie aber sehr ausgeprägt sein und Werte von 20-40 x 109/L erreichen. Die eosinophilen Granulozyten sind meist morphologisch unauffällig.